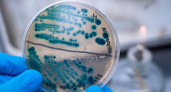
Абигьи Ананда: мир накроет опасный вирус

Автор материалов: Татьяна Котова
Последние новости
Житель Коми арестован за оправдание теракта на Крымском мосту
14:45Забудьте про красители из пакетиков: 5 рецептов природной палитры для пасхальных яиц - станут как драгоценные камни
14:35Со сходом снега покупаю 3 пачки соли — и не мучаюсь, как городские: подсказал старичок из деревни — дома спокойно всю весну
13:56Укроп взойдет даже у новичков - как правильно посеять зелень, чтобы получить дружные всходы
13:45В Коми стартовало первенство СЗФО по вольной борьбе среди юниоров
13:00В Коми водитель иномарки сбил пенсионерку при движении задним ходом
12:45Ученые огласили самые полезные морепродукты — не креветки, не кальмары и в два раза полезнее икры
12:45Мои находки из Фикс прайс для Пасхи за последнюю неделю - честный обзор
12:30Игнорирование предостережений Россельхознадзора привело предпринимателя к судебному запрету на торговлю
11:27Глаза на лоб полезли: в квитанции ЖКХ заметили новую строку на 1300 рублей — обязаны ли платить все?
11:00Город, основанный в 1861 году: текстильная столица и калейдоскоп шёлковых фабрик — что посмотреть
11:00При появлении первых листочков — обязательно: вношу 1 гр. в воду — и рассада томатов начинает мощный рост
10:47Сугробы в самый разгар весны: Вильфанд предупредил об аномальной погоде в апреле
10:15Сирень в пролёте: этот кустарник радует цветением с лета до зимы и превращает сад в пушистое облачко круглый год
10:02Ленивая клумба: цветы, которые я сею прямо в грунт без рассады
09:44В марте после схода снега засыпаю под куст 1 специальный порошок — и летом смородина ломится от ягод размером с монету
09:42В Коми утвердили график и состав участников Большой недели педагогического мастерства
09:40Жителям Коми разъяснили правила официального трудоустройства на две работы по совместительству в 2026 году
09:39Миграционный контроль в Коми: полиция зафиксировала 55 нарушений в ходе проверок
09:22Жительница Ухты перевела мошенникам 4,5 миллиона рублей после приглашения в "домовой чат"
09:09Житель Коми получил 10 лет колонии за попытку сбыта оптовой партии запрещенных веществ
09:00Запуск радиозонда в Коми обеспечил метеорологов новыми данными об атмосфере
08:55В Коми макароны и яблоки подорожали на 5,6%, а бензин подешевел на 0,2%
08:45Верховный суд дал ответ, можно ли управлять автомобилем без гос рег знаков, даже если автомобиль новый и не был зарегистрирован в ГИБДД
08:12Петуния больше не в моде, нашла вариант лучше: многолетник, который не капризничает
07:50«Через год сбежали с моря обратно в город»: почему мечта о жизни у моря обернулась кошмаром
07:37Общественный совет при Минмолодежи Коми утвердил план работы на 2026 год
07:30Готовлю печень только так, муж не отличает от мяса: бефстроганов в соусе — нежная, сочная и никакой горечи
07:03Жительница Коми заплатит 154 тысячи рублей за выброшенную из окна бутылку
07:00В трех районах Коми введут ограничения из-за пуска ракеты "Союз-2"
06:45Обычные отбивные уже не в моде: готовлю курицу только так — нежнее телятины, сочная, воздушная, этот рецепт меняет всё
06:26Дрожжи в шоке: всего 2 секрета – и тесто выпрыгивает из миски за 25 минут. Поднимается быстрее, чем разогревается духовка
06:03Малине — как космонавту перед полетом: 2 литра под каждый куст в марте — летом ягоды крупнее и слаще муската
05:55Температура в южных районах Коми поднимется до +13 градусов 27 марта
05:45Окна чище, чем после клининга: знакомая уборщица раскрыла несколько секретов
05:03

Абигьи Ананда: мир накроет опасный вирус
6 сентября 2023
Сидик Афган: лишь одну из стран ждет светлое будущее
6 сентября 2023
В Коми мужчина подал в суд на бездействие администрации
6 сентября 2023
В Коми самокатчик сбил двух пешеходов
6 сентября 2023
В Коми пенсионеры не могут записаться к врачу
6 сентября 2023
Врач-диетолог рассказала, какой овощ укрепит иммунитет осенью
5 сентября 2023
В Госдуме предложили ввести дополнительные выходные для некоторых семей
5 сентября 2023
Девушки с этими именами обречены на нищету
5 сентября 2023
Пророчества Нострадамуса: мир ждет глобальные катастрофы
5 сентября 2023
Эти два ингредиента помогут избавиться от влаги и запахов
5 сентября 2023
В Коми в результате ДТП Lada перевернулась на крышу
5 сентября 2023
В Коми женщина потребовала у дочери компенсацию в 1 миллион рублей
5 сентября 2023
Жителям России объяснили новый порядок назначения платных лекарств
4 сентября 2023
